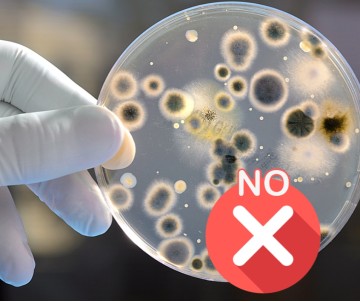
VIAMICROB

PRESERV
- Descrizione breve: COADIUVANTE IN POLVERE AD AZIONE CONSERVANTE
- Produttore: Eska S.r.l.
- Codice prodotto: 0346
- Codice EAN13: 8030643003467
- Confezione: Scatola da 5 Kg
-
Punti premio: 52
- Disponibilità: Prodotto disponibile per la vendita on-line (vedi condizioni di vendita)
Attenzione: L’acquisto ONLINE è possibile SOLO a panifici, pasticcierie e attività similari, titolari di partita Iva
CON SEDE LEGALE IN ITALIA ED IN ALCUNI PAESI EUROPEI (elencati nelle condizioni di vendita).
NON TUTTI I PRODOTTI SONO IN VENDITA.
L'acquisto è infatti possibile SOLO per i prodotti sui quali è visualizzato
il PREZZO PER CONFEZIONE.
L'ordine minimo di acquisto complessivo è di Euro 200 di imponibile
(ovvero IVA esclusa) ovvero composto da uno o più prodotti. I clienti registrati possono godere dei seguenti sconti:
per ordini superiori a Euro 400 di imponibile si applicherà automaticamente lo
sconto del 10%, per ordini superiori a Euro 600 di imponibile, lo
sconto sarà del 15%. Le condizioni complete di vendita sono visualizzabili
alla pagina: https://www.eska.it/termini-e-condizioni.
Leggi tutto
-
Prezzo unitario: 10,70€/Kg + IVA (10%)
Prezzo a confezione: 53,50€ + IVA (IVA non applicabile per l'export)
PRESERV ha proprietà conservanti ed antimuffa. PRESERV si aggiunge direttamente alla salse da conservare o alla farina nel caso di impasti di prodotti dolciari e non interferisce con il normale processo di lavorazione.
PRESERV non altera il gusto del prodotto finito.
DOSAGGIO: Q.B. nel limite massimo dello 0,6% riferito al peso della salsa o dell’impasto da preparare.
UTILIZZO: Aggiungere direttamente alla salsa o alla farina e lavorare come d’abitudine.
tag:
PRESERV,
conservante alimentare,
antimuffa,
preservante per salse,
conservazione impasti,
additivo naturale